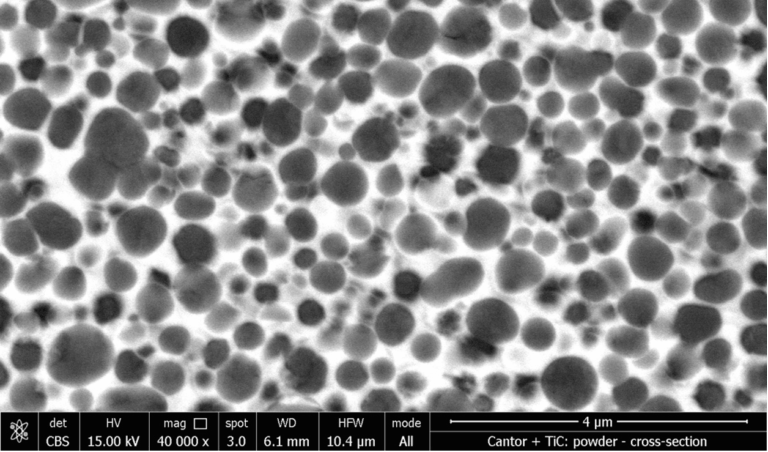
Microstructure of Titanium Carbides in a FeCrAl matrix Microstructure of Titanium Carbides in a FeCrAl matrix

In response to the increasing demand for sustainable, high-performance materials in advanced manufacturing sectors, MBN Nanomaterialia, through collaborative development projects, has successfully engineered a new class of compositionally complex hardmetals based on TiC–FeCrAl matrices. These coatings are specifically developed for thermal spray applications (e.g., HVOF), offering a viable, scalable alternative to conventional WC-Co and Cr₃C₂-NiCr systems that rely heavily on critical raw materials (CRMs) such as cobalt, tungsten, nickel, and chromium.
Market Need & Strategic Context:
Industries reliant on wear-resistant coatings—such as tooling, aerospace, and energy—face mounting pressure due to supply risks and regulatory constraints around CRMs and hazardous materials. The European Union’s policies around CRM reduction and substitution underscore the urgency for alternatives that are both technically competitive and environmentally safer. Additionally, manufacturing processes that involve inhalable Co/Ni powders present significant health hazards, reinforcing the shift toward safer feedstocks.
MBN’s Innovation & Commercial Readiness:
Leveraging its proprietary Mechanomade® synthesis process, MBN developed a Fe-based matrix incorporating in-situ synthesized TiC reinforcements, achieving:
•Superior bonding between matrix and hard phase,
•Elimination of costly post-treatments required by SHS methods,
•Enhanced consistency in chemical and phase composition.
The new FeCrAl-based coatings display competitive wear and corrosion resistance, maintaining integrity under high-stress abrasion and dry sliding conditions up to 600 °C. Importantly, these materials are entirely free of W, Co, and Ni, aligning with occupational safety regulations and CRM policy goals.
Unique Value Proposition:
MBN’s strength lies in its end-to-end control of the powder lifecycle—from synthesis to application testing—across multiple manufacturing platforms (thermal spray, laser cladding, sintering). This integrated approach, combined with scalable industrial production and in-house lab and prototyping capabilities, allows MBN to rapidly translate lab-scale innovation into market-ready solutions.
With its focus on CRM substitution, safety, and performance, MBN is uniquely positioned to deliver next-generation coating materials that meet industry demands for sustainability, reliability, and regulatory compliance, while significantly reducing processing time and energy consumption.